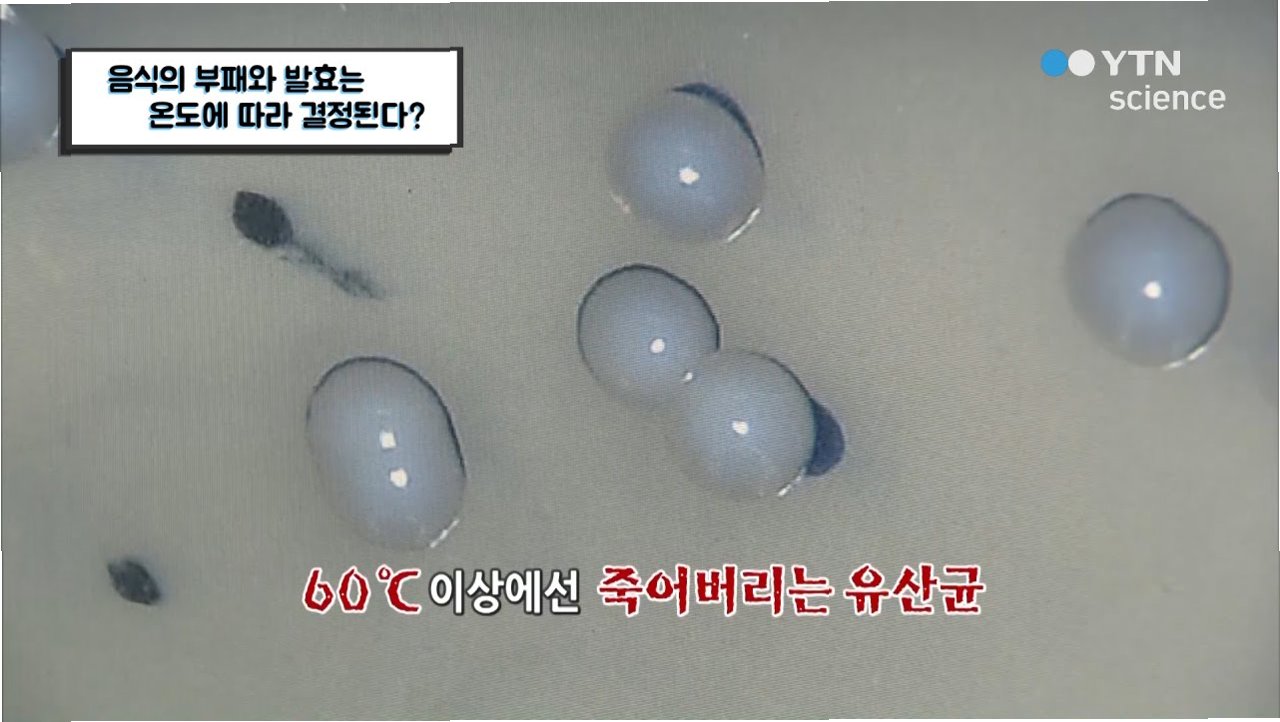

3톤 현금 곰팡이 냄새…'3t 처장'의 부패, 중국을 뒤흔들다
거액의 현금, 썩은 냄새, 그리고 '3t 처장'
중국에서 전직 공무원의 집에서 무려 3톤에 달하는 현금이 발견되는 충격적인 사건이 발생했습니다. 이 사건은 중국 사회에 만연한 부패 문제를 다시금 수면 위로 떠올리게 했습니다. 곰팡이 냄새가 날 정도로 많은 현금은, 단순히 돈의 양을 넘어 부패의 심각성을 시각적으로 보여주는 지표가 되었습니다. 이 사건으로 인해, 해당 공무원은 '3t 처장'이라는 불명예스러운 별명으로 불리게 되었습니다.

IPO 심사 실세, 권력의 그림자
주목할 점은, 이 공무원이 중국 증시의 기업공개(IPO) 심사를 담당했던 인물이라는 것입니다. 그는 '중국판 나스닥'으로 불리는 창업판 IPO 심사 업무의 실세 역할을 하며, 한때 '살아있는 염라대왕'으로 불릴 정도로 막강한 영향력을 행사했습니다. 그의 한마디에 기업 상장이 좌우될 정도였다고 하니, 그 권력이 얼마나 컸는지 짐작할 수 있습니다. 이러한 권력을 이용하여 그는 은밀하게 부를 축적했습니다.

사직 후에도 이어진 부패, '도피형 사직'의 그림자
2016년 개인적인 사유로 사직한 후, 그는 전직 직위를 이용하여 상장 예정 기업의 비상장 주식을 매입하는 방식으로 거액을 챙긴 것으로 조사되었습니다. 이는 현직에서 물러난 후에도 권력을 이용하여 재산을 축적하는 이른바 '도피형 사직'의 전형적인 사례로 지목되고 있습니다. 그의 부패 행위는, 공직에서 물러난 후에도 지속될 수 있는 부패의 끈을 보여주며, 중국 사회의 뿌리 깊은 부패 문제를 다시 한번 드러냈습니다.

시진핑의 반부패 노력과 현실의 괴리
시진핑 주석은 집권 초기부터 반부패를 강조하며 공직 기강 확립에 힘썼습니다. 2012년에는 반부패 방지 공무원 지침인 8항 규정을 만들었고, 지난 7월에도 부패 척결을 강조했습니다. 그러나 이러한 노력에도 불구하고, 공직자들의 부패는 끊임없이 적발되고 있습니다. 이번 사건은 시진핑 주석의 노력과 현실 사이의 괴리를 보여주는 씁쓸한 단면입니다.

부패는 어떻게 만연해지는가: 권력, 유혹, 그리고 감시의 부재
이번 사건은 부패가 어떻게 만연하는지를 보여주는 여러 요소를 담고 있습니다. 막강한 권력, 돈에 대한 유혹, 그리고 이를 감시하고 통제하는 시스템의 부재가 복합적으로 작용한 결과입니다. 이러한 요소들이 결합하여, '3t 처장'과 같은 부패 사건을 만들어냅니다. 부패는 개인의 일탈을 넘어, 사회 전체의 시스템 문제임을 시사합니다.
중국 사회가 풀어야 할 숙제: 부패 척결과 투명성 확보
이번 사건은 중국 사회가 해결해야 할 숙제를 다시 한번 일깨워줍니다. 부패 척결을 위한 지속적인 노력과 더불어, 투명성을 확보하고 공정한 경쟁 환경을 조성하는 것이 중요합니다. 이를 위해, 부패 방지 시스템을 강화하고, 감시와 처벌을 더욱 엄격하게 적용해야 합니다. 또한, 공직자들의 윤리 의식을 높이고, 부정부패에 대한 사회적 경각심을 높이는 노력도 필요합니다.

핵심만 콕!
중국에서 3톤의 현금이 발견된 전직 공무원 사건은 부패의 심각성을 보여주는 사례입니다. IPO 심사 실세였던 그의 권력 남용과 '도피형 사직'은, 시진핑 주석의 반부패 노력에도 불구하고 만연한 부패 문제를 드러냅니다. 부패 척결과 투명성 확보를 위한 지속적인 노력이 필요한 시점입니다.

자주 묻는 질문
Q.왜 3톤의 현금이 발견된 사건이 이렇게 큰 파장을 일으키나요?
A.단순히 돈의 양이 많다는 것을 넘어, 부패의 심각성을 시각적으로 보여주기 때문입니다. 또한, IPO 심사 담당자의 부패라는 점에서, 중국 경제 전반에 대한 불신을 야기할 수 있기 때문입니다.
Q.시진핑 주석의 반부패 노력은 효과가 없는 건가요?
A.반부패 노력에도 불구하고, 지속적으로 부패 사건이 발생한다는 것은, 그 노력이 아직 충분하지 않다는 것을 의미합니다. 부패는 뿌리 깊은 문제이므로, 지속적이고 강력한 노력이 필요합니다.
Q.이 사건이 중국 사회에 미치는 영향은 무엇일까요?
A.사회 전반의 불신을 야기하고, 공정성에 대한 의문을 제기할 수 있습니다. 또한, 정부의 정책에 대한 불신으로 이어질 수 있으며, 경제 성장에도 부정적인 영향을 미칠 수 있습니다.
